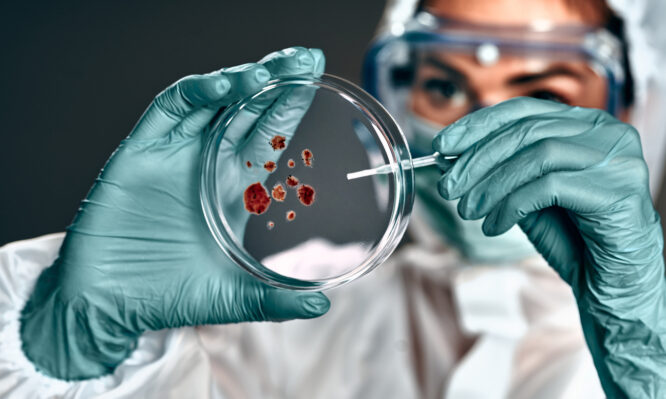
χολέρα

Χολέρα: Πώς η μάχη βακτηρίων και βακτηριοφάγων ιών εξηγεί τη σοβαρότητα και την εξάπλωσή της νόσου
Η χολέρα παραμένει μια από τις πιο επικίνδυνες λοιμώδεις ασθένειες παγκοσμίως, με εκατομμύρια περιστατικά κάθε χρόνο και χιλιάδες θανάτους, ιδιαίτερα σε περιοχές με περιορισμένη πρόσβαση σε καθαρό νερό και υποδομές υγείας. Αν και η αιτία της νόσου είναι γνωστή, η συμπεριφορά του παθογόνου μικροοργανισμού εξακολουθεί να κρύβει σημαντικά ερωτήματα.
Μια νέα διεθνής γονιδιωματική μελέτη ρίχνει φως σε έναν κρίσιμο μηχανισμό: τη συνεχή εξελικτική «αντιπαράθεση» ανάμεσα στο βακτήριο της χολέρας και τους ιούς που το μολύνουν. Η αλληλεπίδραση αυτή φαίνεται να επηρεάζει άμεσα τόσο τη σοβαρότητα της νόσου όσο και την παγκόσμια εξάπλωσή της.
Τι είναι η χολέρα και γιατί παραμένει απειλή
Η χολέρα είναι μια ασθένεια, που προκαλείται από βακτήρια που μολύνουν τα έντερα αφού κάποιος έχει καταναλώσει μολυσμένο νερό (ή τρόφιμα). Τα βακτήρια προκαλούν πολύ σοβαρή διάρροια και μερικές φορές έμετο. Η διάρροια είναι τόσο σοβαρή που ένα άρρωστο άτομο αφυδατώνεται γρήγορα και αυτό μπορεί να οδηγήσει σε θάνατο μέσα σε λίγες ώρες.
Η διάρροια των ασθενών με χολέρα περιέχει πολλά βακτήρια χολέρας. Εάν τα λύματα με βακτήρια χολέρας μολύνουν με κάποιο τρόπο το πόσιμο νερό, κάτι που μπορεί να συμβεί πολύ εύκολα, οι εστίες χολέρας μπορούν να εξαπλωθούν εξαιρετικά γρήγορα.
Κάθε χρόνο καταγράφονται περίπου 1,3 έως 4 εκατομμύρια περιστατικά χολέρας και έως 143.000 θάνατοι παγκοσμίως. Η συνεχιζόμενη εξάπλωση της νόσου συνδέεται κυρίως με ένα συγκεκριμένο στέλεχος του βακτηρίου, το 7PET O1, το οποίο εντοπίστηκε αρχικά στην περιοχή του Κόλπου της Βεγγάλης, ανάμεσα στο Μπανγκλαντές και την Ινδία.
Μια νέα εικόνα για την εξάπλωση της νόσου
Η νέα μελέτη, που δημοσιεύθηκε στο περιοδικό Nature την 1η Απριλίου 2026, βασίστηκε σε ανάλυση περισσότερων από 2.300 γονιδιωμάτων βακτηρίων, τα οποία συλλέχθηκαν σε διάστημα περίπου 20 ετών από το Μπανγκλαντές και τη Βόρεια Ινδία.
Στην έρευνα συμμετείχαν επιστήμονες από:
- το Wellcome Sanger Institute στο Ηνωμένο Βασίλειο
- το icddr,b (Διεθνές Κέντρο Έρευνας Διαρροϊκών Νοσημάτων) στο Μπανγκλαντές
- το Post Graduate Institute of Medical Education & Research (PGIMER) στην Ινδία
Τα αποτελέσματα της μελέτης ανέτρεψαν μια βασική αντίληψη για την προέλευση και την εξάπλωση της χολέρας. Για χρόνια, το Δέλτα του Γάγγη θεωρούνταν η κύρια «πηγή» της νόσου σε παγκόσμιο επίπεδο. Ωστόσο, τα νέα δεδομένα δείχνουν ότι τον ρόλο αυτό, της πηγής δηλαδή, παίζει ολόκληρη η ευρύτερη λεκάνη του Γάγγη, που εκτείνεται σε Μπανγκλαντές και Ινδία.
Παράλληλα, η έρευνα δείχνει μια πιο σύνθετη εικόνα για το πώς εξαπλώνεται η χολέρα. Μέχρι σήμερα, επικρατούσε η άποψη ότι η νόσος ακολουθεί κυρίως το νερό, δηλαδή τα ποτάμια και τις υδάτινες διαδρομές. Όμως τα στοιχεία δείχνουν ότι αυτό δεν συμβαίνει πάντα.
Στην πράξη, η εξάπλωση της χολέρας φαίνεται να περιορίζεται συχνά μέσα στα σύνορα μιας χώρας και να μην ακολουθεί απαραίτητα τη ροή των ποταμών. Αυτό υποδηλώνει ότι ο ανθρώπινος παράγοντας, όπως οι μετακινήσεις και η πυκνότητα του πληθυσμού, επηρεάζει περισσότερο τη διασπορά της νόσου από ό,τι το ίδιο το φυσικό περιβάλλον.
Η «μάχη» με τους ιούς που αλλάζει την πορεία της νόσου
Ένα από τα πιο σημαντικά ευρήματα της μελέτης αφορά τη σχέση του βακτηρίου με τους βακτηριοφάγους ιούς, δηλαδή ιούς που μολύνουν βακτήρια.
Συγκεκριμένα, το βακτήριο της χολέρας βρίσκεται σε μια συνεχή «μάχη» με έναν ιδιαίτερο τύπο ιού, τον βακτηριοφάγο ICP1. Οι βακτηριοφάγοι, είναι ιοί που δεν προσβάλλουν τον άνθρωπο, αλλά στοχεύουν αποκλειστικά βακτήρια. Για να επιβιώσουν και να πολλαπλασιαστούν, εισέρχονται μέσα στο βακτήριο, χρησιμοποιούν τους μηχανισμούς του και στο τέλος το καταστρέφουν.
Με άλλα λόγια, πρόκειται για «φυσικούς εχθρούς» των βακτηρίων. Αξίζει να σημειωθεί ότι αυτοί οι ιοί είναι ακίνδυνοι για τον άνθρωπο και υπάρχουν φυσιολογικά στο περιβάλλον, αλλά και στο ανθρώπινο μικροβίωμα, όπου συμμετέχουν στη ρύθμιση των μικροβιακών πληθυσμών.
Πώς εξελίσσεται η «μάχη» ανάμεσα σε βακτήριο και ιό
Η αλληλεπίδραση ανάμεσα στο βακτήριο της χολέρας και τον βακτηριοφάγο ICP1 δεν είναι σταθερή, αλλά αλλάζει διαρκώς. Αναλύοντας δεδομένα περίπου 20 ετών, οι επιστήμονες είδαν ότι το βακτήριο δεν μένει παθητικό απέναντι στον ιό. Αντίθετα είτε αποκτά είτε χάνει συνεχώς συγκεκριμένα γενετικά χαρακτηριστικά, που λειτουργούν σαν άμυνες.
Οι άμυνες δρουν σαν μια «ασπίδα», βοηθώντας το βακτήριο να επιβιώνει όταν δέχεται επίθεση. Την ίδια στιγμή, όμως, και ο ίδιος ο ιός εξελίσσεται, βρίσκοντας νέους τρόπους να ξεπερνά αυτές τις άμυνες και να συνεχίζει να το μολύνει.
Έτσι δημιουργείται ένας συνεχής κύκλος προσαρμογής. Το βακτήριο ενισχύει την προστασία του, ο ιός την παρακάμπτει και η διαδικασία επαναλαμβάνεται. Αυτή η δυναμική «μάχη» επηρεάζει τελικά το πόσο επιθετικό και μεταδοτικό μπορεί να γίνει το βακτήριο για τον άνθρωπο.
Η κρίσιμη ισορροπία: πότε το βακτήριο γίνεται πιο επικίνδυνο
Μέσα σε αυτή τη συνεχή «μάχη» ανάμεσα στο βακτήριο και τον ιό, οι επιστήμονες εντόπισαν μια πολύ σημαντική ισορροπία που επηρεάζει άμεσα τη συμπεριφορά της νόσου.
Όπως προκύπτει από τα δεδομένα, το βακτήριο της χολέρας καλείται ουσιαστικά να «επιλέξει» ανάμεσα στην άμυνα και στην επιθετικότητα. Όταν διατηρεί ισχυρούς μηχανισμούς προστασίας απέναντι στον βακτηριοφάγο, καταφέρνει να επιβιώνει καλύτερα απέναντι στον ιό. Ωστόσο, αυτή η άμυνα φαίνεται να έχει ένα κόστος. Τα στελέχη αυτά προκαλούν συνήθως πιο ήπια νόσο στον άνθρωπο και δεν εξαπλώνονται εύκολα πέρα από τη γεωγραφική περιοχή όπου εμφανίζονται.
Αντίθετα, όταν το βακτήριο χάνει αυτές τις άμυνες, αλλάζει η συμπεριφορά του. Γίνεται πιο επιθετικό για τον ανθρώπινο οργανισμό και, ταυτόχρονα, αποκτά μεγαλύτερη ικανότητα να διαδίδεται σε νέες περιοχές, αυξάνοντας τον κίνδυνο ευρύτερης εξάπλωσης.
Η δρ. Άμπερ Μπάρτον, συν-συγγραφέας της μελέτης, εξηγεί ότι αυτή η συνεχής εναλλαγή – η απόκτηση και η απώλεια αμυντικών μηχανισμών – αποτελεί βασικο παράγοντα για να κατανοήσουμε πώς εξαπλώνεται η χολέρα. Με άλλα λόγια, η εξέλιξη του ίδιου του βακτηρίου, μέσα από αυτή τη συνεχή «μάχη» με τον ιό, καθορίζει ποια στελέχη έχουν τη δυνατότητα να εξαπλωθούν ευρύτερα. Και αυτή η εξάπλωση τελικά διαμορφώνεται μέσα στις ανθρώπινες κοινωνίες.
Προς πιο αποτελεσματικά συστήματα πρόληψης
Η καλύτερη κατανόηση της εξέλιξης των στελεχών μπορεί να συμβάλει στη δημιουργία συστημάτων έγκαιρης προειδοποίησης. Μέσα από τη γονιδιωματική παρακολούθηση, θα είναι δυνατό να εντοπίζονται τα στελέχη που έχουν χάσει κρίσιμες άμυνες και ενδέχεται να προκαλέσουν πιο σοβαρές επιδημίες.
Ο καθηγητής Νικ Τόμσον, συν-συγγραφέας της μελέτης, υπογράμμισε ότι η παγκόσμια πανδημία χολέρας συνεχίζεται και ότι το βακτήριο εξελίσσεται διαρκώς. Όπως ανέφερε, η κατανόηση αυτών των εξελικτικών μηχανισμών μπορεί να βοηθήσει στην ανάπτυξη πιο αποτελεσματικών στρατηγικών για τον περιορισμό της νόσου και την προστασία των πληθυσμών.
Φωτογραφία: istock







